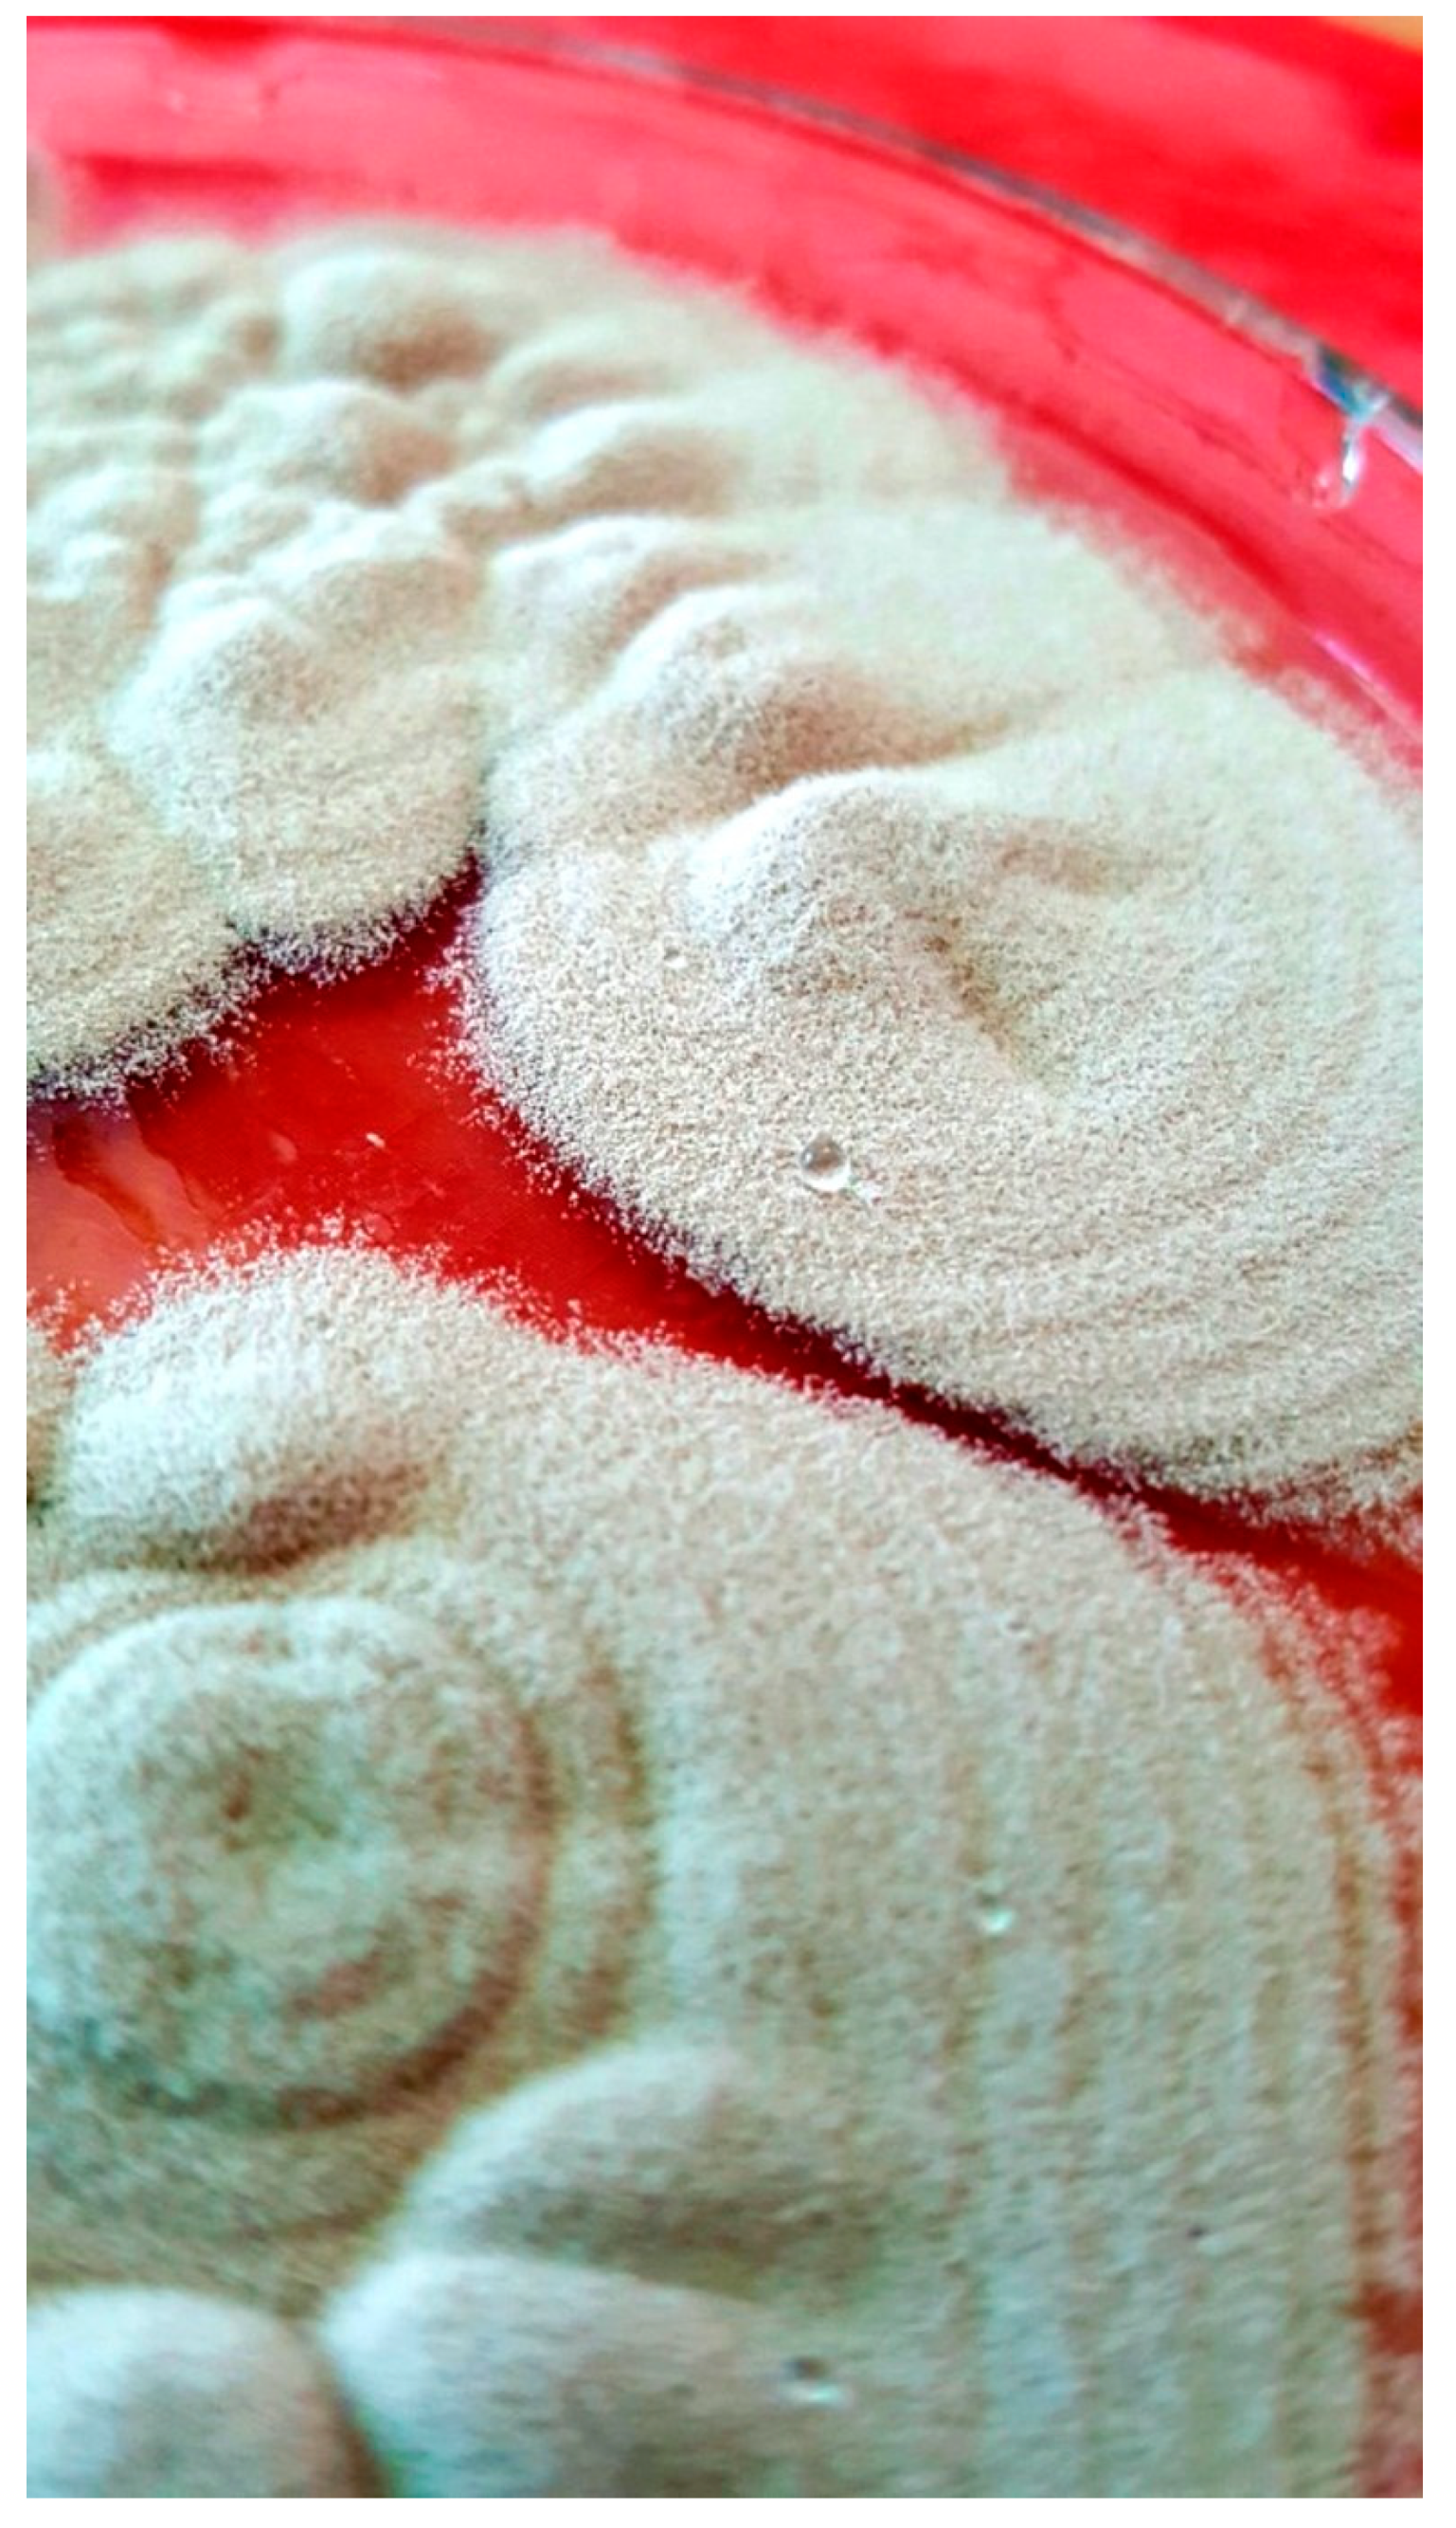
Pathogens 10 01046 g011 Pathogens 10 01046 g011

First Report of a Case of Ocular Infection Caused by Purpureocillium lilacinum in Poland
Abstract
1. Introduction
2. Materials and Methods
2.1. Culture
2.2. Drug Susceptibility
2.3. Results
3. Results
4. Discussion
5. Conclusions
Author Contributions
Funding
Institutional Review Board Statement
Informed Consent Statement
Data Availability Statement
Acknowledgments
Conflicts of Interest
References
- Brown, L.; Leck, A.K.; Gichangi, M.; Burton, M.J.; Denning, D.W. The global incidence and diagnosis of fungal keratitis. Lancet Infect. Dis. 2021, 21, e49–e57. [Google Scholar] [CrossRef]
- Ting, D.S.J.; Ho, C.S.; Deshmukh, R.; Said, D.G.; Dua, H.S. Infectious keratitis: An update on epidemiology, causative microorganisms, risk factors, and antimicrobial resistance. Eye 2021, 35, 1084–1101. [Google Scholar] [CrossRef] [PubMed]
- Thomas, P.A.; Kaliamurthy, J. Mycotic keratitis: Epidemiology, diagnosis and management. Clin. Microbiol. Infect. 2013, 19, 210–220. [Google Scholar] [CrossRef] [PubMed]
- Mahmoudi, S.; Masoumi, A.; Ahmadikia, K.; Tabatabaei, S.A.; Soleimani, M.; Rezaie, S.; Ghahvechian, H.; Banafsheafshan, A. Fungal keratitis: An overview of clinical and laboratory aspects. Mycoses 2018, 61, 916–930. [Google Scholar] [CrossRef] [PubMed]
- Manikandan, P.; Abdel-Hadi, A.; Singh, Y.R.B.; Revathi, R.; Anita, R.; Banawas, S.; Bin Dukhyil, A.A.; Alshehri, B.; Shobana, C.S.; Selvam, K.P.; et al. Fungal Keratitis: Epidemiology, Rapid Detection, and Antifungal Susceptibilities ofFusariumandAspergillusIsolates from Corneal Scrapings. BioMed Res. Int. 2019, 2019, 1–9. [Google Scholar] [CrossRef]
- Haghani, I.; Amirinia, F.; Dailami, K.N.; Shokohi, T. Detection of fungi by conventional methods and semi-nested PCR in patients with presumed fungal keratitis. Curr. Med. Mycol. 2015, 1, 31–38. [Google Scholar] [CrossRef]
- Yera, H.; Ok, V.; Kuet, F.L.K.; Dahane, N.; Ariey, F.; Hasseine, L.; Delaunay, P.; Martiano, D.; Marty, P.; Bourges, J.L. PCR and culture for diagnosis of Acanthamoeba keratitis. Br. J. Ophthalmol. 2020, 316730. [Google Scholar] [CrossRef]
- Shimizu, D.; Miyazaki, D.; Ehara, F.; Shimizu, Y.; Uotani, R.; Inata, K.; Sasaki, S.-I.; Inoue, Y. Effectiveness of 16S ribosomal DNA real-time PCR and sequencing for diagnosing bacterial keratitis. Graefes Arch. Clin. Exp. Ophthalmol. 2020, 258, 157–166. [Google Scholar] [CrossRef]
- Todokoro, D.; Hosogai, M.; Nakano, S.; Akiyama, H. Effective diagnosis by real-time PCR of herpes simplex diffuse endotheliitis that is similar in appearance to fungal keratitis: Case series. J. Ophthalmic Inflamm. Infect. 2021, 11, 1–5. [Google Scholar] [CrossRef] [PubMed]
- Sikora, M.; Kuthan, R.; Piskorska-Malolepsza, K.; Golas-Pradzynska, M.; Domański, D.; Augustynowicz-Kopeć, E.; Swoboda-Kopec, E. Prevalence and Antifungal Susceptibility of the Emerging Fungal Species, Candida nivariensis, Isolated in a Teaching Hospital in Poland. Pol. J. Microbiol. 2019, 68, 303–308. [Google Scholar] [CrossRef]
- Haynes, K.A.; Westerneng, T.J.; Fell, J.W.; Moens, W. Rapid detection and identification of pathogenic fungi by polymerase chain reaction amplification of large subunit ribosomal DNA. Med. Mycol. 1995, 33, 319–325. [Google Scholar] [CrossRef] [PubMed]
- Kalkanci, A.; Ozdek, S. Ocular Fungal Infections. Curr. Eye Res. 2010, 36, 179–189. [Google Scholar] [CrossRef]
- Gajjar, D.U.; Pal, A.K.; Ghodadra, B.K.; Vasavada, A.R. Microscopic Evaluation, Molecular Identification, Antifungal Susceptibility, and Clinical Outcomes inFusarium, Aspergillusand, Dematiaceous Keratitis. BioMed Res. Int. 2013, 2013, 1–10. [Google Scholar] [CrossRef][Green Version]
- Burgos-Blasco, B.; Gegúndez-Fernández, J.A.; Díaz-Valle, D. Purpureocillium lilacinum fungal keratitis: Confocal microscopy diagnosis and histopathology correlation. Med. Clín. 2020. [Google Scholar] [CrossRef]
- Bader, O. Fungal Species Identification by MALDI-ToF Mass Spectrometry. Adv. Struct. Saf. Stud. 2016, 1508, 323–337. [Google Scholar] [CrossRef]
- Xuguang, S.; Zhixin, W.; Zhiqun, W.; Shiyun, L.; Ran, L. Ocular Fungal Isolates and Antifungal Susceptibility in Northern China. Am. J. Ophthalmol. 2007, 143, 131–133. [Google Scholar] [CrossRef] [PubMed]
- Ribeiro, C.R.; Silva, B.P.; Costa, A.D.A.A.; Neto, A.B.; Vieira, L.A.; de Lima, M.A.; de Lima, M.H.C. Ocular Sporotrichosis. Am. J. Ophthalmol. Case Rep. 2020, 19, 100865. [Google Scholar] [CrossRef]
- Farjo, Q.A.; Farjo, R.S.; Farjo, A.A. Scytalidium Keratitis. Cornea 2006, 25, 1231–1233. [Google Scholar] [CrossRef]
- Homa, M.; Manikandan, P.; Saravanan, V.; Revathi, R.; Anita, R.; Narendran, V.; Panneerselvam, K.; Shobana, C.S.; Al Aidarous, M.; Galgóczy, L.; et al. Exophiala dermatitidis Endophthalmitis: Case Report and Literature Review. Mycopathology 2018, 183, 603–609. [Google Scholar] [CrossRef]
- Sahay, P.; Goel, S.; Nagpal, R.; Maharana, P.K.; Sinha, R.; Agarwal, T.; Sharma, N.; Titiyal, J.S. Infectious Keratitis Caused by Rare and Emerging Micro-Organisms. Curr. Eye Res. 2020, 45, 761–773. [Google Scholar] [CrossRef]
- Tarka, P.; Borowska-Solonynko, A.; Brzozowska, M.; Nitsch-Osuch, A.; Kanecki, K.; Kuthan, R.; Garczewska, B. No-Touch Automated Room Disinfection after Autopsies of Exhumed Corpses. Pathogens 2020, 9, 648. [Google Scholar] [CrossRef]
- Rai, M.; Ingle, A.P.; Ingle, P.; Gupta, I.; Mobin, M.; Bonifaz, A.; Alves, M. Recent advances on mycotic keratitis caused by dematiaceous hyphomycetes. J. Appl. Microbiol. 2021, 15008. [Google Scholar] [CrossRef] [PubMed]
- Tangmonkongvoragul, C.; Chokesuwattanaskul, S.; Tananuvat, N.; Pongpom, M.; Upaphong, P.; Saysithidej, S.; Niparugs, M.; Chongkae, S. The Clinical Features and Prognostic Factors for Treatment Outcomes of Dematiaceous Fungal Keratitis over 9 Years at a Tertiary Eye Care in Northern Thailand. J. Fungi 2021, 7, 526. [Google Scholar] [CrossRef] [PubMed]
- Szczotka-Flynn, L.B.; Shovlin, J.P.; Schnider, C.M.; Caffery, B.E.; Alfonso, E.C.; Carnt, N.A.; Chalmers, R.L.; Collier, S.; Jacobs, D.S.; Joslin, C.E.; et al. American Academy of Optometry Microbial Keratitis Think Tank. Optom. Vis. Sci. 2021, 182–198, Publish Ahead of Print. [Google Scholar] [CrossRef]
- Kredics, L.; Narendran, V.; Shobana, C.S.; Vágvölgyi, C.; Manikandan, P. Indo-Hungarian Fungal Keratitis Working Group Filamentous fungal infections of the cornea: A global overview of epidemiology and drug sensitivity. Mycoses 2015, 58, 243–260. [Google Scholar] [CrossRef] [PubMed]
- Hoffman, J.; Burton, M.; Leck, A. Mycotic Keratitis—A Global Threat from the Filamentous Fungi. J. Fungi 2021, 7, 273. [Google Scholar] [CrossRef] [PubMed]
- Castano, G.; Elnahry, A.G.; Mada, P.K. Fungal keratitis. In StatPearls; StatPearls Publishing: Treasure Island, FL, USA, 2021. [Google Scholar]
- Chen, C.-A.; Hsu, S.-L.; Hsiao, C.-H.; Ma, D.H.-K.; Sun, C.-C.; Yu, H.-J.; Fang, P.-C.; Kuo, M.-T. Comparison of fungal and bacterial keratitis between tropical and subtropical Taiwan: A prospective cohort study. Ann. Clin. Microbiol. Antimicrob. 2020, 19, 1–8. [Google Scholar] [CrossRef]
- Chew, R.; Dorman, A.; Woods, M.L. Purpureocillium lilacinum keratitis: A case series and review of the literature. Can. J. Ophthalmol. 2016, 51, 382–385. [Google Scholar] [CrossRef]
- Perdomo, H.; Cano-Lira, J.F.; Gené, J.; Garcia, D.; Hernández, M.; Guarro, J. Polyphasic analysis of Purpureocillium lilacinum isolates from different origins and proposal of the new species Purpureocillium lavendulum. Mycology 2013, 105, 151–161. [Google Scholar] [CrossRef]
- Purpureocillium lilacinum. Available online: https://mycology.adelaide.edu.au/descriptions/hyphomycetes/purpureocillium/ (accessed on 17 August 2021).
- Yildiz, E.H.; Ailani, H.; Hammersmith, K.M.; Eagle, R.C.; Rapuano, C.J.; Cohen, E.J. Alternaria and Paecilomyces Keratitis Associated With Soft Contact Lens Wear. Cornea 2010, 29, 564–568. [Google Scholar] [CrossRef]
- Pastor, F.; Guarro, J. Clinical manifestations, treatment and outcome of Paecilomyces lilacinus infections. Clin. Microbiol. Infect. 2006, 12, 948–960. [Google Scholar] [CrossRef] [PubMed]
- Moreira, D.C.; Oliveira, M.M.E.; Borba, C.M. Human Pathogenic Paecilomyces from Food. Microorganisms 2018, 6, 64. [Google Scholar] [CrossRef] [PubMed]
- Suzuki, R.; Kiniwa, Y.; Shirai, T.; Takazawa, Y.; Natori, T.; Mochizuki, T.; Okuyama, R. Successful treatment of cutaneous infection due to Purpureocillium lilacinum using voriconazole. J. Dermatol. 2020, 47, 47. [Google Scholar] [CrossRef]
- Swami, T.; Pannu, S.; Kumar, M.; Gupta, G. Chronic invasive fungal rhinosinusitis by Paecilomyces variotii: A rare case report. Indian J. Med. Microbiol. 2016, 34, 103–106. [Google Scholar] [CrossRef] [PubMed]
- Calvillo-Medina, R.P.; Ponce-Angulo, D.G.; Raymundo, T.; Müller-Morales, C.A.; Escudero-Leyva, E.; Guillén, J.C.; Lucio, V.M.B. Purpureocillium roseum sp. nov. A new ocular pathogen for humans and mice resistant to antifungals. Mycoses 2021, 64, 162–173. [Google Scholar] [CrossRef] [PubMed]
- Walther, G.; Zimmermann, A.; Theuersbacher, J.; Kaerger, K.; von Lilienfeld-Toal, M.; Roth, M.; Kampik, D.; Geerling, G.; Kurzai, O. Eye Infections Caused by Filamentous Fungi: Spectrum and Antifungal Susceptibility of the Prevailing Agents in Germany. J. Fungi 2021, 7, 511. [Google Scholar] [CrossRef]
- Borman, A.M.; Fraser, M.; Palmer, M.D.; Szekely, A.; Houldsworth, M.; Patterson, Z.; Johnson, E.M. MIC Distributions and Evaluation of Fungicidal Activity for Amphotericin B, Itraconazole, Voriconazole, Posaconazole and Caspofungin and 20 Species of Pathogenic Filamentous Fungi Determined Using the CLSI Broth Microdilution Method. J. Fungi 2017, 3, 27. [Google Scholar] [CrossRef] [PubMed]
- Clinical and Laboratory Standards Institute. M38-A2: Reference Method for Broth Dilution Antifungal Susceptibility Testing of Filamentous Fungi; Approved Standard, 2nd ed.; CLSI: Wayne, PA, USA, 2008. [Google Scholar]
- Anderson, K.L.; Mitra, S.; Salouti, R.; Pham, T.-A.; Taylor, H. Fungal Keratitis Caused by Paecilomyces lilacinus Associated With a Retained Intracorneal Hair. Cornea 2004, 23, 516–521. [Google Scholar] [CrossRef]
- Kuthan, R.; Chabros, Ł.; Sawicka-Grzelak, A.; Młynarczyk, G. Identification of rod-shaped Gram-negative bacilli of Enterobacteriaceae family by MALDI-TOF mass spectrometry. Postępy Nauk. Med. 2015, 28, 274–276. [Google Scholar] [CrossRef]
- Kierzkowska, M.; Majewska, A.; Kuthan, R.; Sawicka-Grzelak, A.; Młynarczyk, G. A comparison of Api 20A vs MALDI-TOF MS for routine identification of clinically significant anaerobic bacterial strains to the species level. J. Microbiol. Methods 2013, 92, 209–212. [Google Scholar] [CrossRef]
- Szymanek-Majchrzak, K.; Mlynarczyk, A.; Kuthan, R.; Sawicka-Grzelak, A.; Majchrzak, K.; Kawecki, D.; Kosieradzki, M.; Durlik, M.; Deborska-Materkowska, D.; Paczek, L.; et al. Significance of Screening Tests and the Incidence of New Delhi Metallo-beta-lactamase-Producing Gram-negative Bacilli in the Surgery and Transplantation Wards of a Warsaw Medical Center During the Period from April 2014 to May 2017. Transplant. Proc. 2018, 50, 2159–2163. [Google Scholar] [CrossRef]
- Torres-Sangiao, E.; Rodriguez, C.L.; García-Riestra, C. Application and Perspectives of MALDI–TOF Mass Spectrometry in Clinical Microbiology Laboratories. Microorganisms 2021, 9, 1539. [Google Scholar] [CrossRef] [PubMed]
- Rychert, J.; Slechta, E.S.; Barker, A.P.; Miranda, E.; Babady, N.E.; Tang, Y.-W.; Gibas, C.; Wiederhold, N.; Sutton, D.; Hanson, K.E. Multicenter Evaluation of the Vitek MS v3.0 System for the Identification of Filamentous Fungi. J. Clin. Microbiol. 2018, 56. [Google Scholar] [CrossRef] [PubMed]
- Ong, H.S.; Corbett, M.C. Corneal infections in the 21st century. Postgrad. Med. J. 2015, 91, 565–571. [Google Scholar] [CrossRef] [PubMed]
- Yuan, X.; Wilhelmus, K.R.; Matoba, A.Y.; Alexandrakis, G.; Miller, D.; Huang, A.J. Pathogenesis and Outcome of Paecilomyces Keratitis. Am. J. Ophthalmol. 2009, 147, 691–696. [Google Scholar] [CrossRef] [PubMed]
- Chen, Y.-T.; Yeh, L.-K.; Ma, D.H.K.; Lin, H.-C.; Sun, C.-C.; Tan, H.-Y.; Chen, H.-C.; Chen, S.-Y.; Sun, P.-L.; Hsiao, C.-H. Paecilomyces/Purpureocillium keratitis: A consecutive study with a case series and literature review. Med. Mycol. 2020, 58, 293–299. [Google Scholar] [CrossRef]
- Monden, Y.; Sugita, M.; Yamakawa, R.; Nishimura, K. Clinical experience treating Paecilomyces lilacinus keratitis in four patients. Clin. Ophthalmol. 2012, 6, 949–953. [Google Scholar] [CrossRef]
- Guo, L.-N.; Wang, H.; Hsueh, P.-R.; Meis, J.F.; Chen, H.; Xu, Y.-C. Endophthalmitis caused by Purpureocillium lilacinum. J. Microbiol. Immunol. Infect. 2019, 52, 170–171. [Google Scholar] [CrossRef]
- Martinez, E.; Vandergriff, T.; Vasquez, R. Cutaneous Paecilomyces infection in an immunocompromised patient in the setting of postthrombotic syndrome successfully treated with posaconazole. JAAD Case Rep. 2020, 6, 1144–1146. [Google Scholar] [CrossRef]
- Oliveira, M.A.; Carmo, A.; Rosa, A.M.; Murta, J. Posaconazole in the treatment of refractory Purpureocillium lilacinum (former Paecilomyces lilacinus) keratitis: The salvation when nothing works. BMJ Case Rep. 2019, 12, e228645. [Google Scholar] [CrossRef]
- Gracitelli, C.P.B.; Ferrar, P.V.; Pereira, C.A.P.; Hirai, F.E.; de Freitas, D. A case of recurrent keratitis caused by Paecilomyces lilacinus and treated by voriconazole. Arq. Bras. Oftalmol. 2019, 82. [Google Scholar] [CrossRef] [PubMed]
- Ali, T.K.; Amescua, G.; Miller, D.; Suh, L.H.; Delmonte, D.W.; Gibbons, A.; Alfonso, E.C.; Forster, R.K. Contact-Lens-Associated Purpureocillium Keratitis: Risk Factors, Microbiologic Characteristics, Clinical Course, and Outcomes. Semin. Ophthalmol. 2015, 32, 157–162. [Google Scholar] [CrossRef] [PubMed]
- Todokoro, D.; Yamada, N.; Fukuchi, M.; Kishi, S. Topical voriconazole therapy of Purpureocillium lilacinum keratitis that occurred in disposable soft contact lens wearers. Int. Ophthalmol. 2014, 34, 1159–1163. [Google Scholar] [CrossRef] [PubMed]
- Hübner, L.; Tourtas, T.; Weller, J. Kontaktlinsenassoziierte oberflächliche stromale Keratitis durch Paecilomyces lilacinus. Ophthalmologe 2021, 118, 180–183. [Google Scholar] [CrossRef] [PubMed]
- Mclintock, C.A.; Lee, G.; Atkinson, G. Management of recurrent Paecilomyces lilacinus keratitis. Clin. Exp. Optom. 2013, 96, 343–345. [Google Scholar] [CrossRef]
- Chen, W.; Lin, S.; Hung, S. Successful Treatment of Recurrent Cutaneous Purpureocillium lilacinum (Paecilomyces lilacinus) Infection with Posaconazole and Surgical Debridement. Acta Derm. Venereol. 2019, 99, 1313–1314. [Google Scholar] [CrossRef]

Publisher’s Note: MDPI stays neutral with regard to jurisdictional claims in published maps and institutional affiliations. |
© 2021 by the authors. Licensee MDPI, Basel, Switzerland. This article is an open access article distributed under the terms and conditions of the Creative Commons Attribution (CC BY) license (https://creativecommons.org/licenses/by/4.0/).
Share and Cite
Kuthan, R.; Kurowska, A.K.; Izdebska, J.; Szaflik, J.P.; Lutyńska, A.; Swoboda-Kopeć, E. First Report of a Case of Ocular Infection Caused by Purpureocillium lilacinum in Poland. Pathogens 2021, 10, 1046. https://doi.org/10.3390/pathogens10081046
Kuthan R, Kurowska AK, Izdebska J, Szaflik JP, Lutyńska A, Swoboda-Kopeć E. First Report of a Case of Ocular Infection Caused by Purpureocillium lilacinum in Poland. Pathogens. 2021; 10(8):1046. https://doi.org/10.3390/pathogens10081046
Chicago/Turabian StyleKuthan, Robert, Anna K. Kurowska, Justyna Izdebska, Jacek P. Szaflik, Anna Lutyńska, and Ewa Swoboda-Kopeć. 2021. "First Report of a Case of Ocular Infection Caused by Purpureocillium lilacinum in Poland" Pathogens 10, no. 8: 1046. https://doi.org/10.3390/pathogens10081046
APA StyleKuthan, R., Kurowska, A. K., Izdebska, J., Szaflik, J. P., Lutyńska, A., & Swoboda-Kopeć, E. (2021). First Report of a Case of Ocular Infection Caused by Purpureocillium lilacinum in Poland. Pathogens, 10(8), 1046. https://doi.org/10.3390/pathogens10081046

